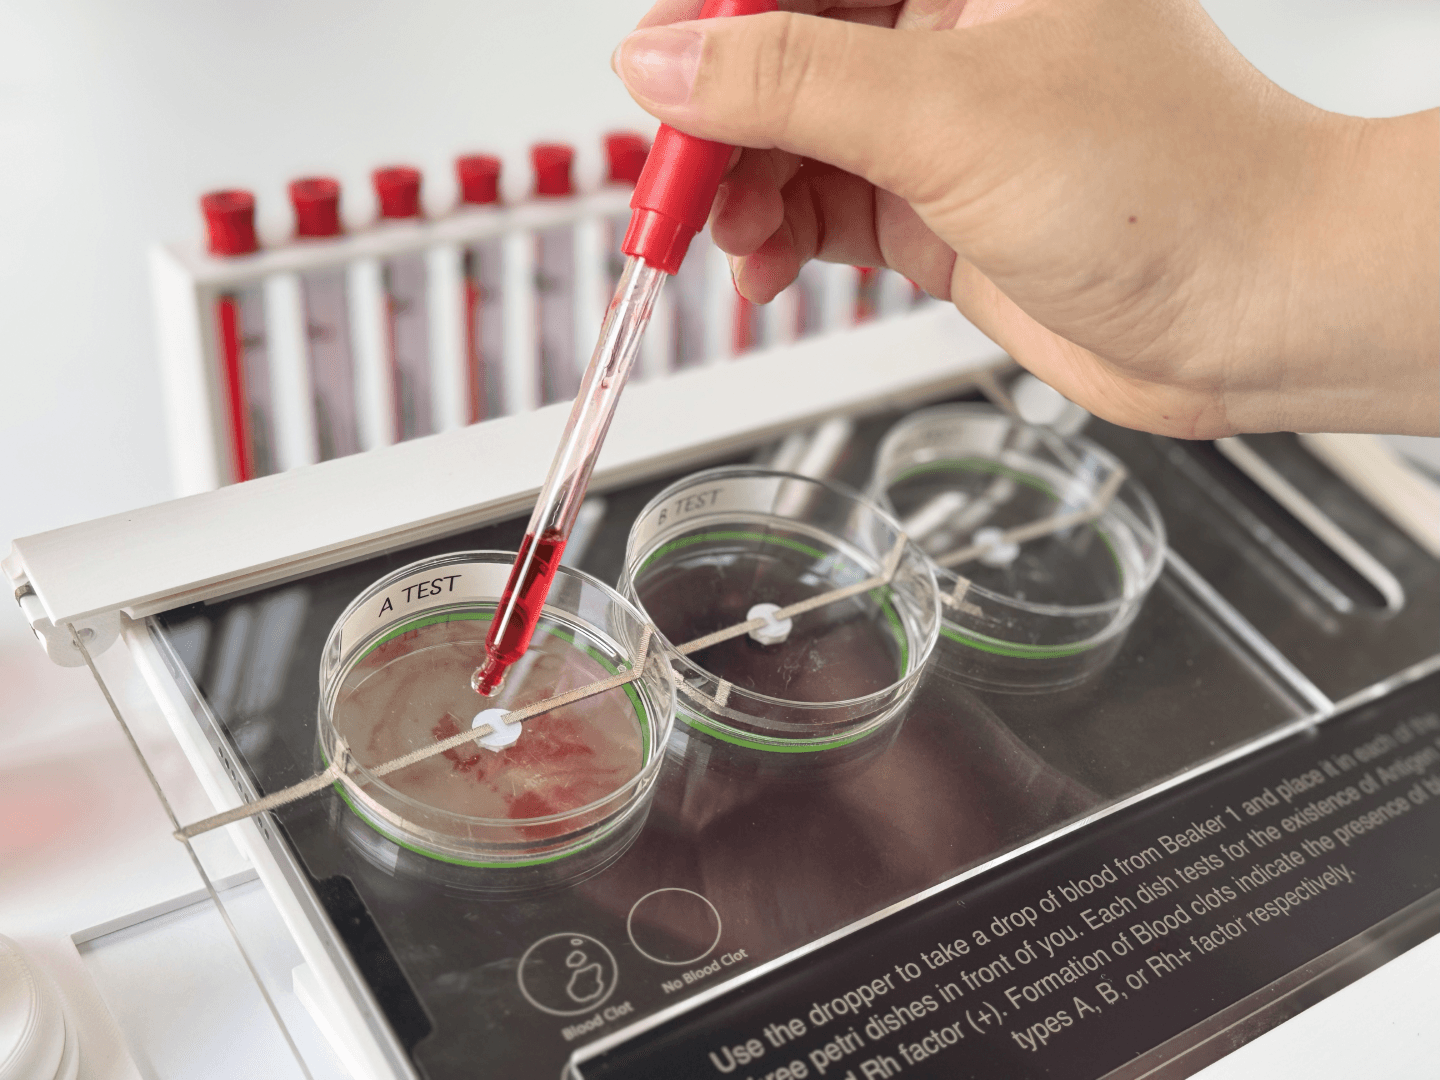
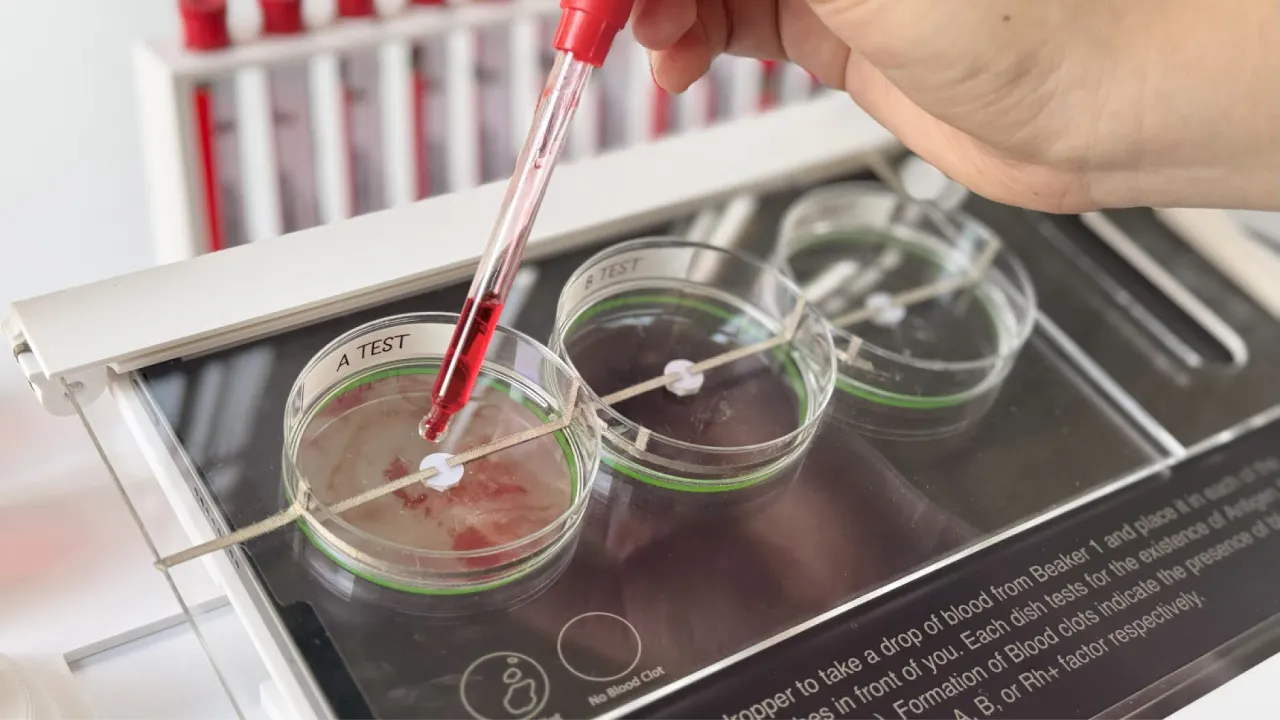

Blood Type Decoder
Bridging the gap between education and entertainment, the Blood Type Decoder transforms the science of blood types and inheritance into a playful, hands-on exploration.
Category
Product/ Interactive Design
Duration
11 Weeks
Year
2024
Blood Type Decoder
Bridging the gap between education and entertainment, the Blood Type Decoder transforms the science of blood types and inheritance into a playful, hands-on exploration.
Category
Product/ Interactive Design
Duration
11 Weeks
Year
2024

I. The "At a Glance" Summary
Project Title | Team Details | Duration & Context | Key Deliverables | Methods & Tools Used |
|---|---|---|---|---|
Blood Type Decoder | A 2-person team consisting of the following members: | One academic semester of 11 Weeks from August to November 2024, |
|
|
II. The Deep Dive: Process and Rationale
A. Discovery & Research
Most of us know that blood is essential for survival, but unlike common traits like hair or eye color, it isn’t something you can discover and distinguish by appearance alone. Given that blood compatibility is a matter of life and death, possessing this knowledge is critical. However, traditional education often relies on static textbooks that fail to engage. Thus, this project identifies an opportunity to bridge that gap, moving beyond rote learning to foster a deeper understanding of blood typing through playful, interactive exploration.
Blood is essentially classified into these eight types below.
Blood Type | Antigens on Red Blood Cell | Rh Factor |
A+ | A | Positive |
A- | A | Negative |
B+ | B | Positive |
B- | B | Negative |
AB+ | A and B | Positive |
AB- | A and B | Negative |
O+ | None | Positive |
O- | None | Negative |
Blood typing determines compatibility by testing samples against three specific antibodies: Anti-A, Anti-B, and Anti-Rh. In this process, blood is added to separate petri dishes containing these antibodies. If the corresponding antigens are present, the blood reacts by clumping together, visually revealing the specific blood type. This process informed and grounded the first phase of our project.
Going beyond simple identification, the project deepens the learning experience by investigating blood inheritance. It demystifies the logic of heredity, allowing users to apply genotype combinations and probability models to understand how blood traits are genetically transmitted across generations.
Here, genotype is the underlying genetic code (e.g., AO), while phenotype is the resulting visible trait (e.g., Blood Type A).

How it works:
- A and B are dominant genotypes.
- O is recessive genotypes.
- Therefore, a parent with Type A blood could be AA (pure) or AO (carrying the hidden O gene) and this means two parents with blood type A can possibly have a child with either blood type A or O, depending on genotype combinations.
These formed the basis of our second project phase, where we worked to develop a simplified yet still enjoyable process for learning genotype pairings and inheritance rules.
B. Define & Ideate
Problem Statement: "How might we simplify blood type learning and make it fun, engaging, and inclusive?".
Context and Target Users:

To ensure the relatability and playfulness of our product, we drew inspiration from actual blood typing tests and DNA extraction machines for the specific interactions involved. Using red liquids, experiment gestures, and tools resembling scientific apparatus, it captures the fun of hands-on science while simplifying this complex concept.
![]() | ![]() |
![]() | ![]() |
C. Develop, Prototype & Refine
Quick Overview of our prototyping process
![]() | ![]() |
![]() | ![]() |
III. Final Product & Reflection


The Blood Type Decoder reimagines the way we understand blood by simplifying complex scientific concepts into a hands-on, exploratory learning experience. Through simulated blood typing and inheritance experiments, this project engages users in uncovering the science behind blood types. By combining physical setups that mimic real scientific experiments with interactive digital interfaces, users can observe simulated antigen-antibody reactions to identify and understand blood types. The experience is further enriched by the “Genotype Machine,” which lets users decode inheritance patterns through playful, interactive gestures. Designed for home learning and blood donation drives, the Blood Type Decoder bridges education and entertainment, making the essential knowledge of blood types both accessible and impactful through tangible interaction.
This project taught me how to translate complex scientific ideas into clear, engaging interactions. Leading the project’s concept development and coding pushed me to simplify antigen–antibody reactions and inheritance rules without losing accuracy—an ongoing balance refined through user testing and multiple redesigns, especially after some actual play testing at the Science Centre. Working closely with my team also strengthened my ability to integrate differing perspectives, turning debates into better design decisions. Troubleshooting technical issues under time pressure further built my confidence in staying calm and solution-driven.
Value Creation
By merging physical experimentation with interactive digital feedback, the Blood Type Decoder makes the science of blood types intuitive, playful, and accessible. It creates value for both home learners and blood donation drives by transforming abstract biomedical concepts into hands-on, memorable experiences.
Future Vision
Moving forward, the system could expand into a modular educational toolkit with additional blood group systems, adaptive difficulty levels, and more seamless digital-physical integration. With further refinement, the Decoder has strong potential to grow into a scalable platform that brings biomedical learning to a wider audience through tangible, exploratory play.








